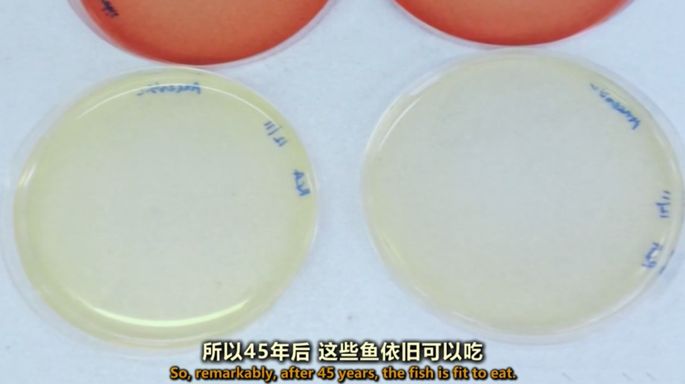
上海|想花1折的钱，买到进口的精致生活？跟着上海阿姨走就对了

上海四川北路不停改造,
开开关关的店太多了,
很多店还没记住名字就关门了。
四十年来,唯一屹立不倒的店铺,
有且只有一家,那就是:

图 / 上海市民生活指南
店门口最打眼的地方,
进口食品琳琅满目。
德国酸奶、法国干红、泰国甜甜圈、
日本曲奇、韩国辣酱、马来西亚饼干等等,
进口货品密密麻麻堆放一起,
像是联合国代表正在大合照。

图 / 新民晚报
这些进口货,都快要过期了,
无一例外便宜得吓人:
5L装葵花油,40元,保质期剩下3个月,
抱一桶回家,煎炸不用愁。
凹造型必备的星爸爸咖啡,
便利店十几元一瓶,这只要5块,
咖啡自由唾手可得。
法国干红最便宜一瓶20元就有交易,
划算得看不懂,不喝洋酒的人也跃跃欲试。

说到临期食品,自然少不得经放的罐头。
上海梅林午餐肉,家乐福卖15元,
新海的单价只要10元。
一次买3盒午餐肉,
还送一盒同品牌的番茄酱。
回去做剪火腿蛋、做麻辣香锅,
都是感人的大满足。
时不时播出促销信息,
路过不买,总觉得亏了。
北京人惊叹:
“这是琉璃厂,食品界的。”
海外代购姑娘说:
“食品奥特莱斯,no problem。”

不管春夏秋冬,
门口都聚着一群爷叔阿姨,
买起来都是以箱来计算。
大爷大妈疯狂买起来,
压根儿就没网红奶茶店什么事。
围着一堆淘宝上搜不到的进口货,
素不相识的老人们凑在一起,
开始一场生活经验交流会。
开小踏板过来的爷叔,
坚信“一日一可可,医生远离我”。
尝过众多叫不出名字欧洲巧克力,
他发现可可含量70%巧克力里,
法国产的完胜同价位的比利时货。

图 /上海市民生活指南
正当爷叔带着老花镜看可可含量,
旁边一个年过六旬的阿姨,
跟营业员聊起了“美食经”。
她不是附近居民,
特意开电瓶车过去的,
就为了买几瓶德国黑啤烧菜。
她介绍说那款啤酒,
用来烧肉烧鱼,色香味俱全。
靠近这些热爱生活的老人家身边,
随便听几耳朵,
你立即解锁如下技能:

上海人的精明、实惠、小资,
都在这一堆进口食品前展露无遗。
贫穷限制了你的精致生活?
不不不,上海爷叔和阿姨们是不会同意的。

营业员跟顾客强调赠品。图 / 新民晚报
这家店保留90年代商场的经营模式,
都是你先挑选看好,营业员来给你装袋。
这里的营业员都是上海阿姨,
很有眼力劲,会察言观色。
你眼角扫了下德国啤酒,
正犹豫着一个女生喝不完,
营业员阿姨会及时送来温馨提示:
我上回烫发,发质干得不行,
拿一罐啤酒洗头,立即顺滑很多。
想起上周刚做的挑染,
一打啤酒说买就买。

图 / 上海市民生活指南
孝顺女儿陪妈妈去新海商城,
都得提前约法三章:
不帮忙拿东西,不要买太重的液体,
一次消费不能超过200块……
最后总消费额稳稳控制在199块,
主要原因是实在拎不动。
没有健身习惯的少男少女们,
请不要轻易挑战陪爸妈去新海。
这不像给偶像打榜,
熬夜体质在这里不适用。

买年货的人群。
除了门口的开架特卖,
往里面走走,还有柜台卖金华火腿、
老香斋苔条梗、红房子朗姆蛋糕、
老大房鲜肉月饼、国际饭店蝴蝶酥……
跟南京路一店一样的老字号食品,
真材实料,从不打折。
春节来临前,店门口店里面都人挤人,
大家都去备年货,买香肠火腿干果蜜饯等。
到中秋前,鲜肉月饼柜台也是要排队的。

今年6月,新海食品商城也搬迁了,
往北挪了300多米,但是生意依然火爆。
买买买的顾客,常年占据人行道,
让纯粹路过的人们几乎无路可走,
这一情况甚至被附近居民投诉上了新闻。

搬迁公告。
四川北路开了很多家进口食品店。
有人说新海的选品不如那些后起之秀,
也有人说老字号买来更放心。
无论你站哪一家,
吃货路过四川北路,
估计选择买,还是选择买。

上海是南来北往的集散地,
人们从五湖四海来到这里生活、创业,
寻求更好的发展机遇。
与此同时,北方干货和南方特产,
也跟随移民的步伐来到这座城市,
组成大大小小的南北货店。

叶大昌是新海食品商城的母公司。上世纪二十年代,叶大昌所卖的土产、南北货和糟醉食品,在行业中独树一帜。
南货店通常备有几十种食品,
比如杭州家家户户自制的酱鸭,
上海人做腌笃鲜时必不可少的咸肉,
宁波人走到哪里都会怀念的黄鱼鲞,
梅干菜烧肉里的绍兴梅干菜……

现在的新海食品商城,
过去的名字是

至今已有二三十年历史。
南货店最风光的时候,
全上海有87家。
短短800米不到的石门一路,
就开着三家南货店。

过年时,总要去兜一兜的南货店。
七八十年代,南货店间竞争激烈,
看着就像神仙打架。

是苏州人开的一家南货店,
选品严格把关,促销招数清奇。
店员用枣子、桂圆、核桃等做成盆景,
一盆一字,四盆一组,
合为一句吉祥话,像“福禄寿喜”。
大超市的商品造景,融入零食店的文案思维,
这不都为了你过年多买两种干果。

三阳盛算是最早引进电子秤的店家。在称周围加装玻璃罩,是为了避免电扇的风影响秤的精确度。卖南货卖出了科学的实验精神来。
靠近南京西路口,你能看到另一家南货店:

前店后工场,自产自销福建肉松。
尽管有卓越的单品,
但还是得靠应时食品,冲一冲销售额。
炎炎夏日卖西瓜,店门放几只大箩筐,
营造新鲜采摘的田地即视感。
新海商城门口摆货的逻辑,
估计也是从前辈那里继承的。

进入新世纪,
老字号搬迁的搬迁,倒闭的倒闭。
实体店铺的生意,
受到网络电商的冲击,
江浙沪包邮区更是首当其冲。
乡愁突袭,不用跑南货店,
掏出手机就能买遍全中国。
同时由于城市空间的外扩,
像四川北路这般的三大商圈之一,
也不复从前那样红红火火。
与此同时,上海这座城市,
正在从全国大城市,走向全球城市。
上海港近年稳居世界货运量第一大港,
每天进口的外国货品多如牛毛。
远渡重洋,遇到船期的耽误,
一到港可能就临近保质期,那就尴尬啦。

连锁大超市爱惜牌子,品控严格,
例如,保质期是3年,生产出来过了1年,
有的店家就会不收货。
这些临保食品将以极低价格转给小店,
否则,它们都要被丢弃,造成巨大的浪费。
这就是临保进口食品价格这么低的原因。
近水楼台,新海食品商城调整经营,
这些年增加进口食品的特卖,
至少留住那批喜欢逛商场的老顾客。

按照我国法律规定,
商家不允许售卖过期食品,
然而,过期食品并不代表不能吃。
英国BBC节目组联合大学实验室,
检验了一罐过期45年的鱼罐头。
掀开盖子的刹那,油光闪亮,香气扑鼻,
完全看不出年过半百的衰颓样子。
小鱼样本在细菌培养皿里呆了5天,
也没有细菌生长的迹象。
主持人当场试吃后,至今健在。
《走进工厂》节目截屏,试吃45年前的罐头鱼。
在欧洲,由于人们对保质期的误解,
30%至50%的超市食品,
处于猪能吃人也能吃的状态,
就被当垃圾丢掉,造成严重的浪费。
在日本,许多食品的“赏味期限”特别短,
有的薯片仅有2个月,刚买回来就临期。
过了“赏味期限”的食品,可以吃吗?
日本农林水产省,相当于我国农业部,
给出的标准答案是:可以!
如果没有异常的颜色和气味,
还是可以吃的。

日本农林水产省的官网截图。
日本速食食品工业协会说,
许多赏味期限标注为五六个月的方便面,
事实上在保存8-10个月后,口感其实差不多。
全球每年浪费的食物价值达上万亿美元,
重量超过13亿吨,而临期食品是其中的重要部分。
当你把临期食品买回家,

参考资料:
1. 《我们对进口食品的认知,被这些阿姨爷叔颠覆了》李斤欠斤欠. 上海市民生活指南. 2019-5-21
2. 《上海这家老字号南货店卖疯了 价廉物美每一款都是心头爱》侬好上海. 2019-06-04
3. 《上海记忆:南货店》丁老师. 新民网. 2014-03-25
4. 《走进工厂:焗豆》. BBC. 2018-08-09
《日本的“赏味期限”就是“保质期”吗?》. 走舌. 2017-03-30
5. 《四川北路的这家食品店里囥着上海人的“生活经”,这是属于他们的“小乐惠”》. 新民晚报. 2019-06-02
本文部分图片来自网络